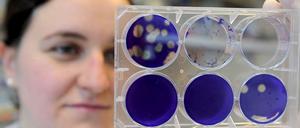

Von Afrika in die Welt: Unsere Vorfahren lebten bereits vor mindestens 80000 Jahren im heutigen Südchina. Europa besiedelten sie erst viel später.

Von Afrika in die Welt: Unsere Vorfahren lebten bereits vor mindestens 80000 Jahren im heutigen Südchina. Europa besiedelten sie erst viel später.

Beim jüngsten Weltraumepos aus Hollywood werden wieder alle Register gezogen. Kann das sein, was da gezeigt wird? Lesen Sie hier einen Faktencheck. Spoilerfrei.

Ein Schwede, ein Amerikaner, ein Türke - und ziemlich unterschiedliche Lebenswege. Lesen Sie hier mehr über die drei Geehrten.

Alle im Mars-Fieber: Auch wenn es zahlreiche Ankündigungen zu bevorstehenden Missionen gibt - der Planet hat noch eine Weile Ruhe vor Homo sapiens. Ein Kommentar.

Neutrinos durchqueren Mensch und Materie – und verändern dabei ihre Form. Für diese Entdeckung erhalten Takaaki Kajita und Arthur McDonald den Nobelpreis.

Flugzeugbenzin kann bei Unglücken vielen Menschen das Leben kosten. Forscher haben nun Polymere entwickelt, die den Treibstoff weniger explosiv machen.

Nasa-Forscher haben Hinweise auf flüssiges Wasser auf dem Mars gefunden. Wenn es tatsächlich existiert, dürfte es eine Salzbrühe sein.

Wissenschaftsredakteur Ralf Nestler begründet, warum Blei aus der Jagdmunition verbannt werden sollte. Lesen Sie hier einen Auszug und den vollständigen Beitrag im digitalen Kiosk Blendle.

Seit 40 Jahren ist kein Mensch mehr auf dem Mond gelandet, die Raumfahrt hatte andere Ziele. Nun wollen Experten einen alten Traum verwirklichen. Sie planen eine Station auf dem lebensfeindlichen Erdtrabanten.

Kabelsalat, Zettel, Experimente: Bei einer Panoramatour lässt sich das Innere der Station in aller Ruhe erkunden. Videos und weitere Infos geben einen Eindruck, wie es sich da oben lebt.

Jeder zehnte Tsunamis rast durchs Mittelmeer. Welche Schäden drohen, haben Geoforscher für Küsten auf Seebeben vor Kreta und Sizilien simuliert.

Auch fern der Grenzen von Erdplatten kommt es mitunter zu starken Erschütterungen. Diese "Intraplattenbeben" könnten auf mächtige Ströme im Erdmantel zurückgehen.

Die Angaben zum CO2-Ausstoß Chinas sind umstritten. Eine aktuelle Analyse überrascht: Die Emissionen sind demnach deutlich geringer als gedacht. Eine Ursache sei schlechte Kohle.

Höher als der Eiffelturm ragt die Stahlkonstruktion in den Himmel. Mit zahlreichen Sensoren wollen Forscher dem Klima im und über dem Regenwald auf die Spur kommen. Aber noch fehlen Geräte.

Der strahlende Abfall sollte rasch in der Tiefe verschwinden, aber zugänglich bleiben. Die Kosten für den gesamten Atomausstieg werden die Energieversorger allein kaum bewältigen können. Daher sollte der Staat ihn jetzt komplett übernehmen, bevor es zu spät ist. Ein Kommentar.

Kämpfer des "Islamischen Staats" haben Khaled Asaad getötet und seinen Leichnam zur Schau gestellt. Er hat mehr als 50 Jahre die berühmten Ruinen von Palmyra erforscht.

Die Trockenheit macht Kalifornien zu schaffen. Das Wetterphänomen El Niño könnte etwas Entspannung bringen - aber keine Rettung. Wie sich das Land auf die Dürre einstellt.
Die Robotersonde „Philae“ ist etwa so groß wie eine Waschmaschine. Wo genau sie zum Stehen kam, wissen die Forscher noch immer nicht.

Steinharte Kruste, seltsame Schleifspuren, ein wahrer Baukasten organischer Verbindungen: Die Sonde „Philae“ enthüllt überraschende Geheimnisse des Himmelskörpers Tschuri.
Das "Wissenschaftsbarometer 2015" zeigt, dass insbesondere Themen wie Klimawandel und Gentechnik kritisch gesehen werden. Und jeder Vierte meint, der Einfluss der Wissenschaft auf die Politik sei zu groß.

Bereits in wenigen Jahren könnten autonome Kampfmaschinen einsatzbereit sein, warnen Experten. Groß ist die Gefahr, dass wir die Kontrolle über sie verlieren. Ein Kommentar.

Zweieinhalb Kilometer tief im Meeresgrund leben Mikroben. Ihr Ursprung war vermutlich ein Wald, der vor Jahrmillionen überflutet und verschüttet wurde.

Kepler-452-b: Astronomen finden einen Planeten, der unserer Erde ähnlich ist. Die spannendste Frage können die Nasa-Forscher nicht beantworten.

Der Exoplanet "Kepler-452b" ist der Erde in vielfacher Hinsicht ziemlich ähnlich. Die entscheidende Frage können die Nasa-Experten aber nicht beantworten.
öffnet in neuem Tab oder Fenster